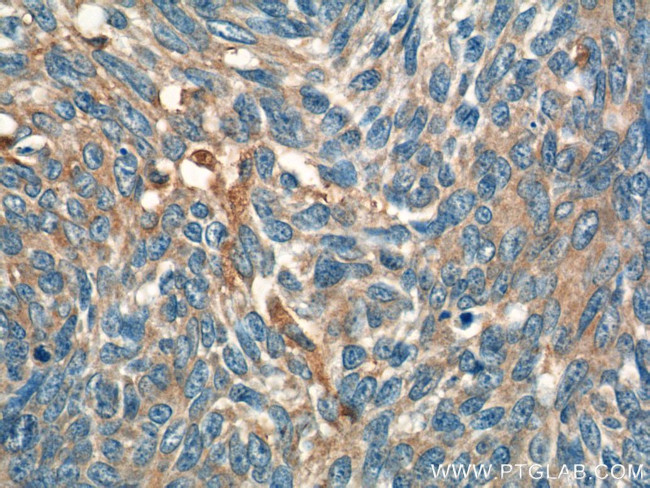
IL-19 Antibody in Immunohistochemistry (Paraffin) (IHC (P))

Search
Proteintech
IL-19 Polyclonal Antibody
{{$productOrderCtrl.translations['antibody.pdp.commerceCard.promotion.promotions']}}
{{$productOrderCtrl.translations['antibody.pdp.commerceCard.promotion.viewpromo']}}
{{$productOrderCtrl.translations['antibody.pdp.commerceCard.promotion.promocode']}}: {{promo.promoCode}} {{promo.promoTitle}} {{promo.promoDescription}}. {{$productOrderCtrl.translations['antibody.pdp.commerceCard.promotion.learnmore']}}
产品信息
23705-1-AP
种属反应
宿主/亚型
分类
类型
抗原
偶联物
形式
浓度
规格
纯化类型
保存液
内含物
保存条件
运输条件
产品详细信息
Immunogen sequence: LRRCLISTD MHHIEESFQE IKRAIQAKDT FPNVTILSTL ETLQIIKPLD VCCVTKNLLA FYVDRVFKDH QEPNPKILRK ISSIANSFLY MQKTLRQCQE QRQCHCRQEA TNATRVIHDN YDQLEVHAAA IKSLGELDVF LAWINKNHEV MFSA (63-215 aa encoded by BC153127)
靶标信息
The protein encoded by this gene is a cytokine that belongs to the IL10 cytokine subfamily. This cytokine is found to be preferentially expressed in monocytes. It can bind the IL20 receptor complex and lead to the activation of the signal transducer and activator of transcription 3 (STAT3). A similar cytokine in mouse is reported to up-regulate the expression of IL6 and TNF-alpha and induce apoptosis, which suggests a role of this cytokine in inflammatory responses. Alternatively spliced transcript variants encoding the distinct isoforms have been described.
仅用于科研。不用于诊断过程。未经明确授权不得转售。
生物信息学
蛋白别名: cytokine; il 19; IL-19; ILN; Interleukin; Interleukin-19; Interleukin19; MDA-1; melanoma differentiation associated protein-like protein; Melanoma differentiation-associated protein-like protein; NG.1; ZMDA1
基因别名: IL-10C; IL19; MDA1; NG.1; ZMDA1
UniProt ID: (Human) Q9UHD0
Entrez Gene ID: (Human) 29949